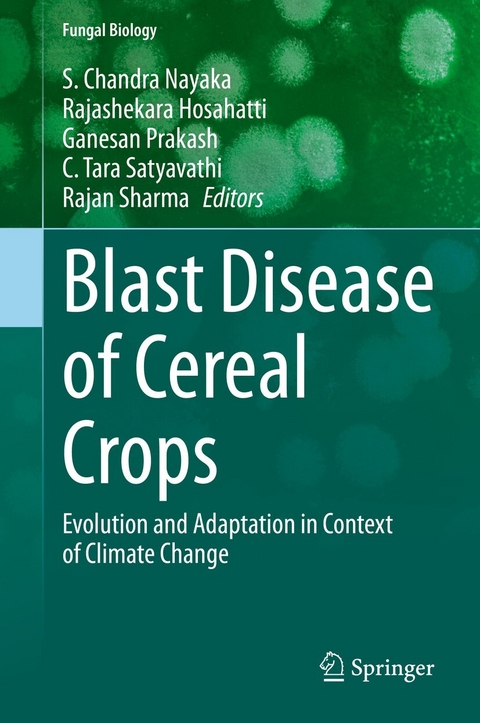
Blast Disease of Cereal Crops -

Blast is an important foliar disease that infects the majority of cereal crops like rice, finger millet, pearl millet, foxtail millet and wheat, and thus resulting in a huge economic impact. The pathogen is responsible for causing epidemics in many crops and commonly shifts to new hosts. Magnaporthe spp. is the most prominent cause of blast disease on a broad host range of grasses including rice as well as other species of poaceae family. To date, 137 members of Poaceae hosting this fungus have been described in Fungal Databases.
This book provides information on all blast diseases of different cereal crops. The pathogen evolves quickly due to its high variability, and thus can quickly adapt to new cultivars and cause an epidemic in a given crop. Some of the topics covered here include historical perspectives, pathogen evolution, host range shift, cross-infectivity, and pathogen isolation, use of chemicals fungicides, genetics and genomics, and management of blast disease in different cereal crops with adoption of suitable methodologies.
In the past two decades there have been significant developments in genomics and proteomics approaches and there has been substantial and rapid progress in the cloning and mapping of R genes for blast resistance, as well as in comparative genomics analysis for resolving delineation of Magnaporthe species that infect both cereals and grass species. Blast disease resistance follows a typical gene-for-gene hypothesis. Identification of new Avr genes and effector molecules from Magnaporthe spp. can be useful to understand the molecular mechanisms involved in the fast evolution of different strains of this fungal genus. Advances in these areas may help to reduce the occurrence of blast disease by the identification of potential R genes for effective deployment.
Additionally, this book highlights the importance of blast disease that infects different cereal hosts in the context of climate change, and genomics approaches that may potentially help in understanding and applying new concepts and technologies that can make real impact in sustainable management of blast disease in different cereal crops.
Dr. S. Chandra Nayaka is an agricultural biotechnology researcher specialized in the application of biotechnological tools in plant protection, pathogen detection and plant-pathogen interaction. He has 20 years of experience in research including visiting scientist at Danish Government Institute of Seed Pathology, Denmark, China Agricultural University, Beijing, China, and he is the Principal Investigator ICAR-AICRP-Pearl millet pathology research.
Working as Professor (ICAR-AICRP-Pearl millet) at University of Mysore in Indian Council of Agricultural Research, responsible for research works on 'pearl millet disease, viz., biology of the pathogen, biochemical and molecular aspects of host-pathogen interaction, epidemiology and management of the disease.' His laboratory is one of the leading research laboratories on pearl millet pathology research in India. His research group is the first group in the world who sequenced full length genome of biotrophic highly virulent strain of S. graminicola. He is recipient of prestigious Japan International Award for Young Agricultural Researchers 2017 and The Millennium Plaques Honor 2019 (Prime Minister Award for Contribution in the field of Science & Technology) by Indian Science Congress Association, DST, Govt. of India. To date, he has more than 2250 research citation with 28 h Index and 60 i10 index. Obtained four national patents for his innovative research projects, published more than hundred research articles in reputed National and International journals, 08 books, 15 book chapters, 03 application notes (Agilent technologies, USA) Six Technical Bulletins, Sixteen short publications/popular articles and submitted more than 1000 nucleotide sequences of seed-borne pathogens and bio-control agents to NCBI-USA, EMBL-Europe and DDBJ-Japan database
Rajashekara H is a Scientist in Plant Pathology currently working at Crop Protection Section, ICAR-Vivekanada Parvatiya Krishi Anusandhan Sansthan, Almora, Uttarakhand, India. His area of interest include race profiling of Magnaporthe oryzae in rice and working on identification of resistant source, variability in blast disease of rice and finger millet. He is also emphasizing on integrated management of disease in major disease of hill crops. He has published 15 peer reviewed research articles, book chapters and extension leaf folders.
Prakash Ganesan is a Scientist in Plant Pathology currently working at Division of Plant Pathology, Indian Agricultural Research Institute, New Delhi, India. His area of specialization is Magnaporthe-Host interaction, Genomics of Magnaporthe spp. and Genome Editing for Blast Resistance. He is also associated with development of blast resistant varieties. Also actively involved in teaching and guiding the students. He has published more than 20 peer reviewed research articles, book chapters, training manuals and other publications also.
Dr. (Mrs). C. Tara Satyavathi completed Ph.D. in the year 1998 from Indian Agricultural Research Institute, New Delhi. Presently she is working as Project Coordinator ICAR - AICRP on Pearl Millet, Rajasthan. She was Principal Scientist in the Division of Genetics, IARI, New Delhi. She has re-oriented pearl millet programme at IARI, developed hybrids (1) and varieties (3), identified QTL(s) for downy mildew resistance, agronomically important traits, developed and identified high grain iron and zinc pearl millet lines, genetic stocks for high lysine, high tryptophan, white grain etc. She developed a number of mapping populations for economically important traits like downy mildew, thermo tolerance, along with a number of white coloured pearl millet lines that are of use in food industry. Dr. Satyavathi received many awards including Dr. Panjabrao Deshmukh outstanding woman scientist award (2016), Outstanding Millet Scientist award (2018), outstanding research contribution in Pearl Millet Improvement in the country (2018) and M.S. Swaminathan Woman Scientist Award (2019) along with many best research paper and best poster awards. She has published 88 research papers in reputed national and international journals. She has written six books and handled 20 research projects financed by DAC, Govt. of India, DBT, AP Cess fund, GLDC Innovation fund, BMGF and ICAR. She has successfully guided three students for Ph.D. degree and eight students for M. Sc degree.
Dr Rajan Sharma is Principal Scientist - Cereals Pathology, and Head of Plant Quarantine unit, at ICRISAT, Patancheru, Hyderabad, Telengana, India. He has obtained his PhD degree from Himachal Pradesh Agricultural University, Palamapur, India and was awarded a Gold medal by Him-utkarsh Society, Una, India. He has made significant contributions in monitoring virulence spectrum of pearl millet pathogens, development of PCR-compatible markers and their use in assessment of genetic diversity of plant pathogens, mapping of avirulence genes, elucidating molecular basis of host-pathogen interaction, identification and utilization of resistance sources for disease management, and capacity building of NARS for management of plant diseases. Dr Rajan Sharma has more than 100 publications including over 70 research articles in several journals of international repute, and has also served as Chief Editor of the Indian Journal of Plant Protection between 2016-2018. As a Head of Plant Quarantine Unit, he liaises with the National Plant Protection Organizations for the smooth exchange of germplasm and breeding material of ICRISAT mandate crops. He is the recipient of ICRISAT Science Award (2014 and 2019) for Outstanding Partnership, and has served as Vice-President of Plant Protection Association of India during 2014-15. He is a member of several International and National Societies in plant protection, including American Phytopathological Society, and Organizing Secretary of International Plant Protection Congress (IPPC) 2019. He is recipient of prestigious International Plant Protection Congress Award for Scientific Achievement (2019) conferred by The International Association for the Plant Protection Sciences (IAPPS) for his contributions 'for developing disease resistant varieties and integrated disease management strategies in cereals for food security in the semi-arid tropics'.
Dr. H. Rajashekara
ICAR - Vivekananda Parvatiya Krishi Anusandhan Sansthan
Department of Plant Pathology
Mall Road, Almora, Uttarakhand 263601, India
rajaiaripath@gmail.com
+91 8791578163
Dr. G. Prakash
ICAR - Indian Agricultural Research Institute
Department of Plant Pathology
New Delhi 110012, India
prakashg.ganesan@gmail.com
+91 8510058871